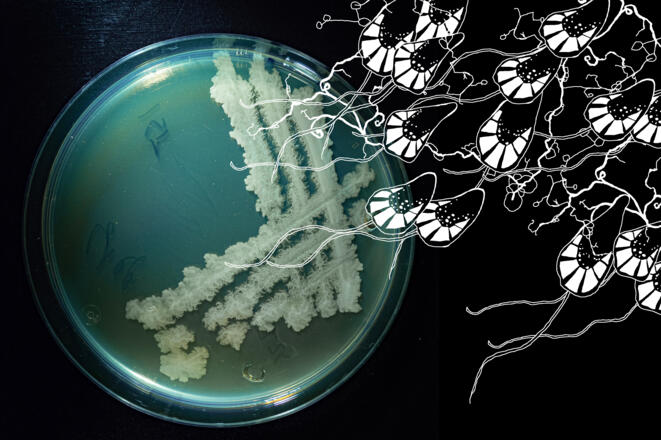

| Quelle | Datacycle |
Judith Saupper & Nadine Präg | Vernissage & Gespräch
Die Veranstaltung
Interventionen: Kunst & Wissenschaft im Dialog.
„Erdungen“ von Nadine Präg und Judith Saupper erkundet die Verbindungen zwischen Mensch und Erde. Durch die Analyse von Bodenproben mittels Mikroorganismenkultivierung und DNA-Sequenzierungen eruiert das Projekt die Möglichkeiten, Böden von Geburts-, Wohn-, Sehnsuchts- und Unorten mit den Hautmikrobiomen von Präg und Saupper zu vergleichen. Kann Zugehörigkeit zu einem Ort, einer Landschaft oder einer Region auf molekularer Ebene sichtbar gemacht werden? Lassen sich die Spuren von Verbundenheit, Vertrautheit und emotionaler Nähe der Protagonistinnen im Mikrobiom eines Ortes lesen?
Ausstellungseröffnung & Gespräche über Morgen: DO 10.07.2025
Ausstellungsdauer: 10.07.2025-26.10.2025
18 Uhr Kunstbox am Jahnplatz.
19 Uhr Palais Liechtenstein.
20 Uhr Judith Saupper und Nadine Präg im Gespräch mit Marlene Nowotny, Ö1 Kunst und Wissenschaft.
Zwei scheinbar unterschiedliche Welten, die oft als Gegensätze wahrgenommen werden. Doch was passiert, wenn sie aufeinandertreffen und gemeinsam nach neuen Antworten auf die Fragen unserer Zeit suchen? In drei Interventionen im Palais Liechtenstein erarbeiten Paare aus Wissenschaft und Kunst eine Ausstellung zu den Themen, die sie bewegen: das Übernatürliche, die Natur, die Künstliche Intelligenz.
Die Gespräche über Morgen laden zu spannenden Diskussionen an der Schnittstelle von Kunst und Wissenschaft! Moderiert werden die Abende von der Ö1-Wissenschaftsmoderatorin Marlene Nowotny.
Eintritt frei. Keine Anmeldung erforderlich.
Mit großzügiger Unterstützung der Raiffeisenbank Montfort.
Eine Veranstaltung im Rahmen des Jubiläumsjahres Feldkirch einhundert, inspiriert von der TU Feldkirch der Montforter Zwischentöne.
Info
Kontakt
|
Schlossergasse 8, 6800 Feldkirch, Österreich
entfernt
|